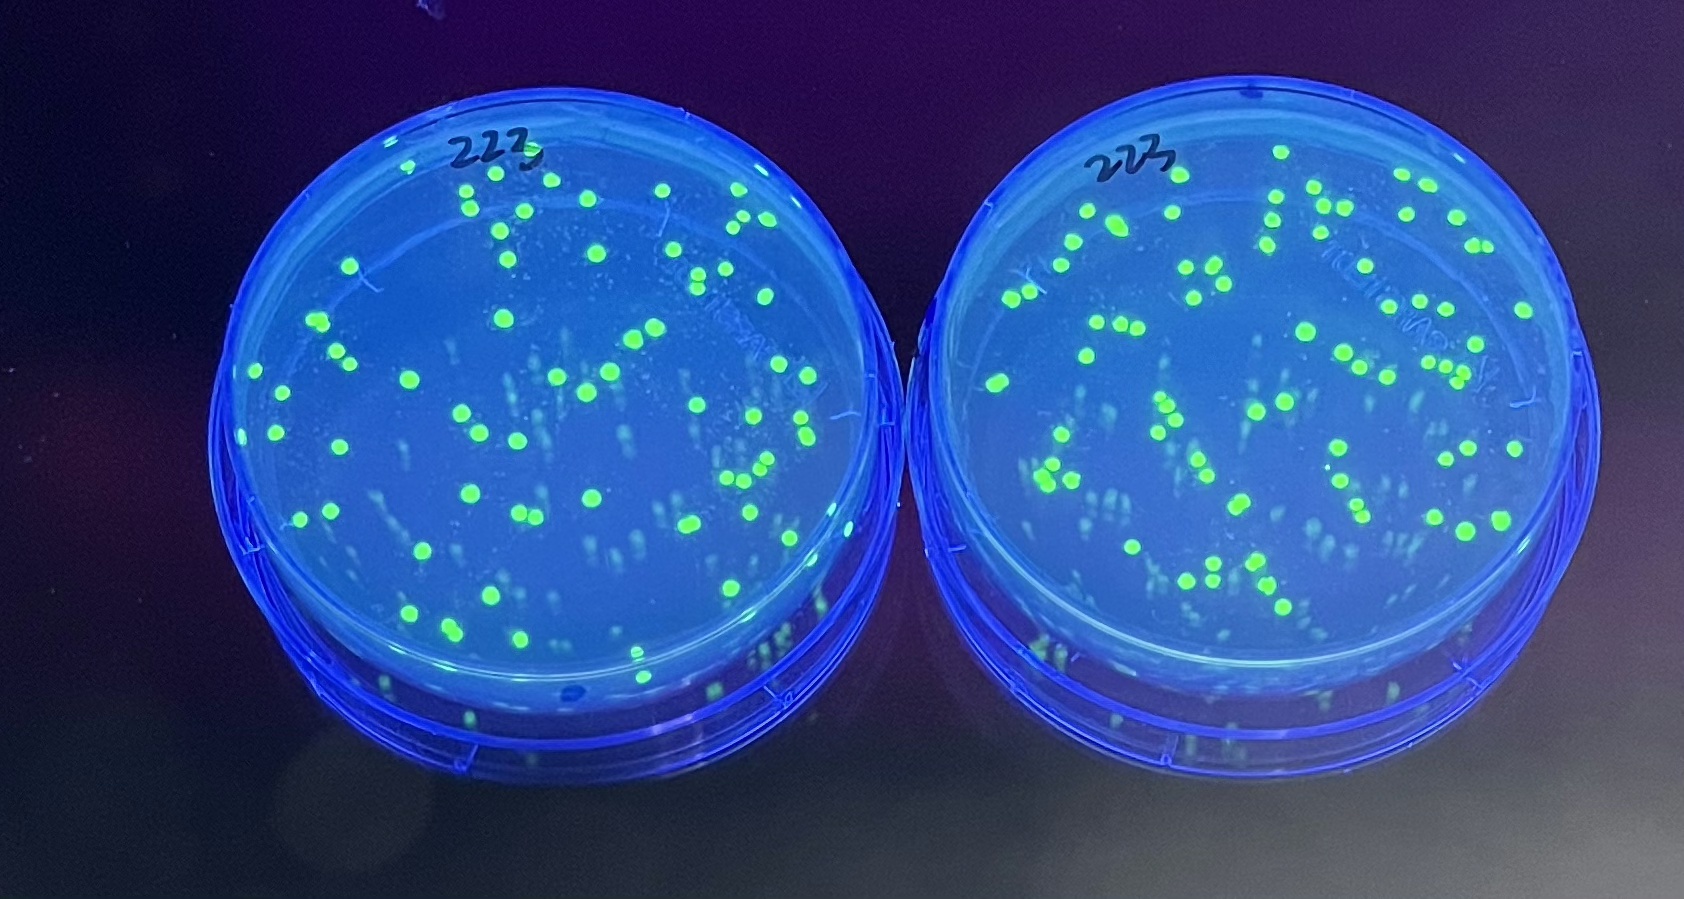

This post is based on a teaching tip submitted by Marian Espola at Inter American University of Puerto Rico, San German Campus. Do you have a teaching tip to share? Submit them here: https://forms.gle/F3rrFjTGeAHhEZCu9
Satellite colonies…. that sounds like something in a science fiction novel, right? But you might be seeing them in your own lab! But what are they, and why do we see them on our transformation plates? And how can we use them as a teaching resource? Read on and we will tell you all about these transformation imposters!
As we’ve discussed here before, transformation is a process through which bacteria acquire exogenous DNA from the environment. This evolved as a mechanism through which microbes can share beneficial genes; however, researchers have figured out a way to engineer DNA in the lab to introduce genes from other organisms into bacteria. These plasmids can essentially reprogram the cells into living factories to create vitamins, proteins, metabolites, and biopharmaceuticals. These plasmids have many features that allow them to grow and multiply within cells.
An important feature for bacterial transformation is a selectable marker, which allows us to identify which bacterial cells have taken up the plasmid and copied it within the cell. In many cases, this selectable marker is a resistance gene to an antibiotic like ampicillin or kanamycin. After we perform the heat shock, the cells are plated on media that contains the antibiotic. Any cells that do not contain the resistance gene will not be able to survive and multiply, forming colonies. This means that every colony on the plate originates from a single transformed cell.
For experiments like our GFP transformation, the plasmid has been engineered to contain the gene for the green fluorescent protein. This is turned on by the promoter in the presence of IPTG, a molecular “on/off” switch. This means that all transformed colonies will appear green, even without the use of a hand-held UV light or a blue light transilluminator. However, if the plates are incubated for longer amounts of time, or even stored in the refrigerator before, you may find small, white colonies pop up next to the transformed colonies. These are our satellite colonies! But what are they, and how do they form?

It’s important to remember that we get individual colonies on our plates because of antibiotic resistance. There is an antibiotic in the agar medium that prevents untransformed cells from growing. However, the enzyme produced by the antibiotic resistance gene in the transformed cells is secreted from the cells into the surrounding medium, where it breaks down the antibiotic. The cells can grow because the transformed cells have reduce the amount of antibiotic in the media. This means that any cells that are still alive but not transformed can start growing and dividing (albeit slowly). And so, we see the “alien” invasion! But really, it’s just normal biological processes at work.

So, can we encourage the growth of satellite colonies? And can we use this phenomenon in the biotechnology lab to teach new techniques? The answers are yes, and yes! One way to encourage the growth of satellite colonies is to incubate the plates at 37ºC for an extra day (so, 48 hours instead of 24). The heat helps to break down the antibiotic because most antibiotics are not heat-stable for long periods of time; the temperature also encourages the enzymatic activity of the secreted enzyme). When we have these colonies on the plates, we can use the polymerase chain reaction (PCR) to analyze the genetic components in the cells. The great thing is that we have developed an experiment (#323, Colony PCR) that allows you to perform this in your classroom to further the discussion of satellite colonies. This set of experiments can be used to link genotype to phenotype, but also to discuss antibiotic resistance and enzyme activity as well! We love experiments that allow us to tie together so many critical concepts and techniques in biotechnology.
Need more transformation teaching resources? Check out these posts:


1 comment
Comments are closed.